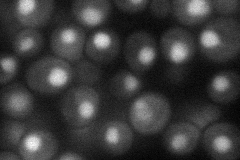
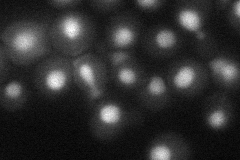

View description
Essential protein with a highly acidic N-terminal domain; IFH1 exhibits genetic interactions with FHL1, overexpression interferes with silencing at telomeres and HM loci; potential Cdc28p substrate
Localization:
Intensity:
Fold change:
Significance:
-
C’ GFP library in SD

nucleus30.97 -
N' NOP1pr-GFP in SD
nucleus45.8286 -
N' TEF2pr-mCherry in SD
nucleus26.3773 -
N' NATIVEpr-GFP in SD

nucleus37.5997 -
N' TEF2pr-VC and Cyto-VN in SD

nucleus,punctate30.0818 -
C’ GFP library in SD+DTT

punctate, nucleusN/AN/ANo -
C’ GFP library in SD+H2O2

nucleus31.441.01No -
C’ GFP library in Starvation Media

nucleus21.750.7Yes -
C’ GFP library on the background of Pup2-DaMP

nucleus -
C’ GFP library on the background of CCT mutant

nucleus41.86911.35174No
